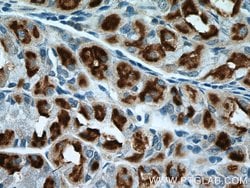
ATP4B Rabbit anti-Human, Mouse, Rat, Polyclonal, Proteintech:Anticuerpos:Anticuerpos

missing translation for 'onlineSavingsMsg'
Learn More
Learn More
Descripción
ATP4B belongs to a family of P-type cation-transporting ATPases. The gastric H+, K+-ATPase is a heterodimer consisting of a high molecular weight catalytic alpha subunit and a smaller but heavily glycosylated beta subunit. This enzyme is a proton pump that catalyzes the hydrolysis of ATP coupled with the exchange of H (+) and K (+) ions across the plasma membrane. It is also responsible for gastric acid secretion. This gene encodes the beta subunit of the gastric H+, K+-ATPase.
Especificaciones
Especificaciones
| Antígeno | ATP4B |
| Aplicaciones | Immunohistochemistry (Paraffin), Western Blot |
| Clasificación | Polyclonal |
| Concentración | 0.15 mg/mL |
| Conjugado | Unconjugated |
| Formulación | PBS with 50% glycerol and 0.02% sodium azide; pH 7.3 |
| génica | ATP4B |
| N.º de referencia del gen | P18598, P50992, P51164 |
| Alias de gen | ATP4B, ATP6B, H+/K+ ATPase beta, Proton pump beta chain |
| Símbolos de los genes | ATP4B |
| Mostrar más |
Título del producto
Al hacer clic en Enviar, acepta que Fisher Scientific se ponga en contacto con usted en relación con los comentarios que ha proporcionado en este formulario. No compartiremos su información para ningún otro fin. Toda la información de contacto proporcionada se mantendrá de acuerdo con nuestra Política de Privacidad. Política de privacidad.
¿Detecta una oportunidad de mejora?